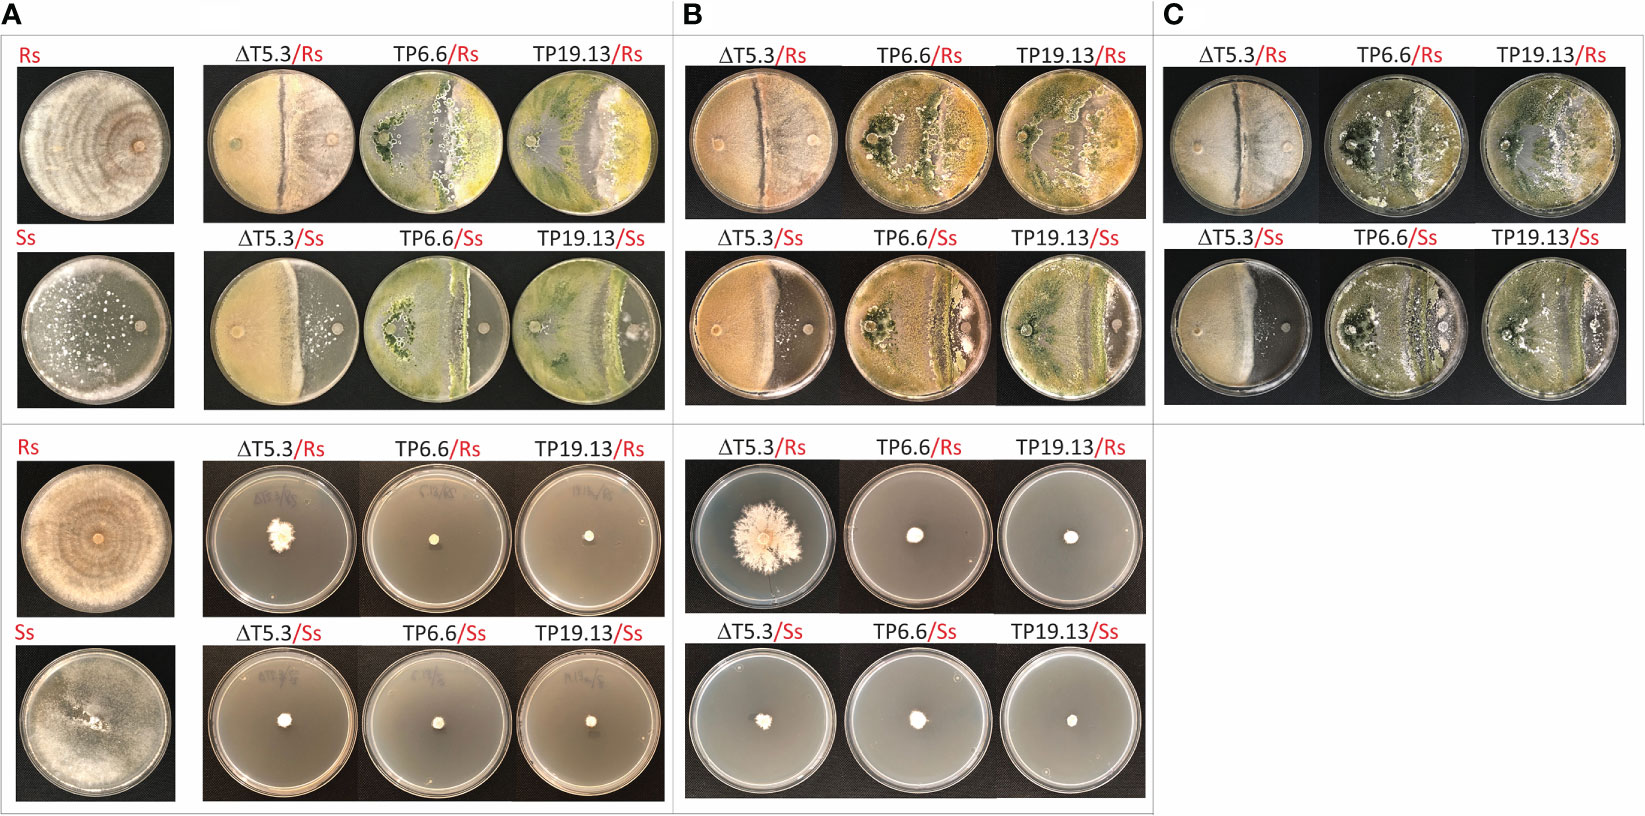

- 1University Group for Research in Engineering and Sustainable Agriculture (GUIIAS), Area of Microbiology, Universidad de León, Ponferrada, Spain
- 2University Group for Research in Engineering and Sustainable Agriculture (GUIIAS), Area of Crop Production, Universidad de León, León, Spain
- 3Mycotoxin Prevention and Applied Microbiology Research Unit, National Center for Agricultural Utiization Research, Agriculture Research Service, U.S. Department of Agriculture, Peoria, IL, United States
The trichothecene toxin-producing fungus Trichoderma arundinaceum has potential as a biological control agent. However, most biocontrol studies have focused only on one strain, IBT 40837. In the current study, three Trichoderma isolates recovered from bean-field soils produced the trichothecene harzianum A (HA) and trichodermol, the latter being an intermediate in the HA biosynthesis. Based on phylogenetic analysis, the three isolates were assigned to the species T. arundinaceum. Their genome sequences had a high degree of similarity to the reference IBT 40837 strain, in terms of total genome size, number of predicted genes, and diversity of putative secondary metabolite biosynthetic gene clusters. HA production by these bean-field isolates conferred significant in vitro antifungal activity against Rhizoctonia solani and Sclerotinia sclerotiorum, which are some of the most important bean pathogens. Furthermore, the bean-field isolates stimulated germination of bean seeds and subsequent growth of above ground parts of the bean plant. Transcriptomic analysis of bean plants inoculated with these T. arundinaceum bean-field soil isolates indicated that HA production significantly affected expression of plant defense-related genes; this effect was particularly significant in the expression of chitinase-encoding genes. Together, these results indicate that Trichoderma species producing non-phytotoxic trichothecenes can induce defenses in plants without negatively affecting germination and development
1 Introduction
The common bean (Phaseolus vulgaris L.) is the third most important food legume worldwide, surpassed only by soybean [Glycine max (L.) Merr.] and peanut (Arachis hypogaea L.). Among southern countries of the European Union, Spain, Italy, and Greece are the main producers of this legume. Within Spain, the province of León is the main bean-producer by quantity and quality, accounting for almost 45% of Spanish bean production in 2018 (Ministerio de Agricultura Pesca y Alimentación, 2019). Socio-economic conditions of the province have enabled maintenance of local varieties in traditional, small-scale cropping systems (Casquero et al., 2006). The high quality of this legume has been awarded with a Protected Geographic Indication (PGI) named Alubia de La Bañeza-León (EC Reg. n. 256/2010 published on 26 March 2010, OJEU L880/17) (Figure S1). In recent years, however, the yield of dry beans in León have been relatively low due, in part, to diseases caused by phytopathogenic fungi and oomycetes (Mayo-Prieto et al., 2015).
Bean crops are susceptible to numerous fungal and oomycete root pathogens, including species of Fusarium, Rhizoctonia, Sclerotinia, Thielaviopsis, Aphanomyces and Pythium. Several of these pathogens can occur as a disease complex (APS, 2010). In the province of León, one of the most frequent bean diseases is “Rhizoctonia root rot” (Valenciano et al., 2006). Several studies have estimated that this disease, together with other related root rots and grey and white molds, can reduce bean yield in León by 50% (Mayo-Prieto et al., 2015).
Over the last two decades, the need for more sustainable strategies to control bean diseases has focused on biological control agents (BCA). Trichoderma spp. are considered among the most promising and frequently studied BCAs (Benitez et al., 2004). In the case of bean diseases, some Trichoderma species have been shown to inhibit development of Rhizoctonia solani and to reduce the effects of this pathogen on plant growth (Mayo-Prieto et al., 2015; Mayo-Prieto et al., 2020a). Furthermore, Trichoderma species have also been used to control nematode and insect pests (Goswami et al., 2008; Rodríguez-González et al., 2017).
In addition to the production of extracellular hydrolytic enzymes (e.g., proteases, cellulases, chitinases, glucanases), Trichoderma spp. produce a plethora of secondary metabolites (SMs) that are diverse in structure and biological activity. These metabolites include peptaibols, lactones, nitriles, polyketides, non-ribosomal peptides, alkaloids, and terpenes (Sivasithamparam and Ghisalberti, 1998; Hermosa et al., 2014). Among the Trichoderma SMs, trichothecenes are a family of approximately 200 toxic sesquiterpenoids that have attracted significant attention in recent years. They are produced by some species in multiple fungal genera, including Fusarium, Isaria, Microcyclospora, Myrothecium, Peltaster, Spicellum, Stachybotrys, Trichoderma and Trichothecium (Proctor et al., 2018; Proctor et al., 2020). Trichothecenes inhibit eukaryotic protein synthesis (Cundliffe et al., 1974; McLaughlin et al., 2009), and some are frequent contaminants of crops used for food and animal feed (O´Donnell et al., 2018). Stachybotrys trichothecenes have been implicated in the harmful effects of mold growth in damp buildings on human health (Straus, 2009). Some trichothecene analogs induce apoptosis (Okumwai et al., 1999), some are phytotoxic, and some act as virulence factors in certain plant-Fusarium interactions (Harris et al., 1999). Many trichothecene-producing fungi are plant pathogens, and some, such as Isaria tenuipes, are insect pathogens. Some Fusarium trichothecenes are among the mycotoxins of most concern to food and feed safety (Desjardins, 2006). In contrast, in vivo studies indicate that trichothecenes produced by Trichoderma arundinaceum and T. albolutescens lack phytotoxicity and contribute to the biological control activity against some plant diseases caused by fungi or viruses (Malmierca et al., 2012; Malmierca et al., 2016; Ryu et al., 2017). Trichoderma arundinaceum trichothecenes, e.g., harzianum A (HA), induce expression of plant genes related to salicylate (SA) and jasmonate/ethylene (JA)/(ET) defense pathways (Malmierca et al., 2012; Malmierca et al., 2013). In addition, HA exhibits strong antifungal activity against several important phytopathogenic fungi (Malmierca et al., 2012; Malmierca et al., 2013). Trichothecenes produced by T. albolutescens (trichodermin and 16-OH-trichodermin) have a protective effect against diseases of tobacco and pepper caused by pepper mottle virus (Ryu et al., 2017).
In addition to the important roles that Trichoderma trichothecenes play in the biological activities of the producing species, they also help to maintain the levels of terpene intermediates, e.g., farnesol, squalene, and ergosterol, needed to ensure normal fungal growth and development (Lindo et al., 2018; Lindo et al., 2019; Gutiérrez et al., 2020).
The current study represents a novel approach to recover trichothecene-producing isolates of Trichoderma from soils in crop fields. In the present case, these strains were isolated from bean fields located in a region of northwestern Spain with the PGI designation Alubia de La Bañeza-León. The selected strains were identified and analyzed using a combination of microbiomics, metabolomics, and comparative genomic techniques. Further, we examined the ability of the resulting isolates to inhibit the growth of the pathogens Rhizoctonia solani and Sclerotinia sclerotiorum, and also analyzed the effects of the isolates on growth and defense response of bean plants. Finally, a transcriptomic study was carried out to assess the effects of HA on expression of defense-related genes in bean.
2 Materials and methods
2.1 Strains used and growth conditions
Pathogens Rhizoctonia solani R43 and Sclerotinia sclerotiorum S47 used for antifungal studies were obtained from the “Pathogens and Antagonists’ collection at the Laboratory for Diagnosis of Pest and Diseases” (University of León, Spain). They were isolated from bean plants grown in a region of the Province of León with the PGI designation of Alubia de La Bañeza-León (Mayo-Prieto et al., 2020b). IBT 40837 (Ta37) is a T. arundinaceum wild-type strain obtained from the fungal culture collection at the Danish Technical University. Strain Δtri5.3 (=ΔT5.3) is a previously described mutant that was generated by deleting the trichothecene biosynthetic gene tri5 in strain IBT 40837 (Gutiérrez et al., 2021). tri5 encodes a terpene synthase (trichodiene synthase) that catalyzes the first commitment step in trichothecene biosynthesis (Malmierca et al., 2013; Gutiérrez et al., 2021). As a result, the deleted tri5 gene in strain Δtri5.3 precludes it from producing harzianum A or any trichothecene biosynthetic intermediates (Gutiérrez et al., 2021).
All fungal strains were grown in potato dextrose agar medium (PDA) (Difco, Becton Dickinson) and incubated at 28°C in the dark. Strains were usually grown for 7 days. However, for some experiments, e.g., antifungal assays, the incubation period was extended as indicated below.
2.2 Trichoderma strains isolation and identification
Soil samples were obtained from seven locations within the PGI Alubia de La Bañeza-León (Figure S1). Five g of soil from each sample, collected at a depth of 10 cm, were processed as previously described (Restovich et al., 2012; Mayo-Prieto et al., 2015; Mayo-Prieto et al., 2020a). Putative Trichoderma isolates were detected on Rose Bengal-chloramphenicol-agar medium (Oxoid, Hampshire, UK) based on morphological characteristics (Mayo-Prieto et al., 2015). The isolates were transferred to PDA plates and sporulated for further characterization.
For fungal identification, a small fraction of PDA-grown mycelium from each fungal isolate was resuspended in 100 μL of the reactive PrepMan Ultra (Applied Biosystems), heated to 100 °C for 10 min and then kept at room temperature for 2 min. Debris was removed by centrifugation for 2 min. Finally, 1 μL of the supernatant was used in the PCR reaction using primers corresponding to the ITS5 (5´-GGAAGTAAAAGTCGTAACAAGG-3´) and ITS4 (5´-TCCTCCGCTTATTGATATGC-3´). PCR was carried out using a GeneAmp PCR 2700 system (Applied Biosystems), and each reaction was performed using the DreamTaq DNA polymerase kit (Thermo Scientific) following the manufacturer´s instructions. After electrophoresis, amplicons were visualized by agarose gel electrophoresis, purified using the NucleoSpin Gel and PCR Clean-up systems (Macherey-Nagel), and then sequenced using the BigDye Terminator v3.1 Cycle kit and an ABI 3130x1 automatic sequencer (Applied Biosystems). For fungal identification, amplified ITS sequences were compared to sequences in the non-redundant GenBank NCBI database (http://www.ncbi.nlm.nih.gov) using the BLASTn program (http://www.ncbi.nlm-.nih.gov/BLAST). To refine the preliminary identification, sequences that yielded the highest scores with Trichoderma species belonging to the Brevicompactum clade (Kubicek et al., 2019; Gutiérrez et al., 2021) were compared to an in-house database consisting of genome sequences from 35 Trichoderma species that correspond to all known trichothecene-producing Trichoderma species and some of their closest relatives (Gutiérrez et al., 2021).
2.3 Detection, quantification of harzianum A (HA)
To assess HA production, the Trichoderma strains selected on the basis of previously described criteria were grown in 250 mL flasks containing 50 mL of complex-malt broth (CM) [0.5% malt extract (Cultimed, Panreac Applichem), 0.5% yeast extract (Difco, Becton Dickinson), 0.5% glucose (Panreac Applichem)], inoculated with 2 x 106 spores/mL and incubated for 48 h at 28°C and 250 rpm in an orbital shaker. 10 mL of this preinoculum were then transferred to a new 250 mL flask containing 50 mL of potato-dextrose broth (PDB) (Difco, Becton Dickinson), and were incubated at 28°C and 250 rpm for 48 h. HA was purified and quantified from the culture supernatants as described by Cardoza et al. (2011). In summary, twenty microliters of the 1:5 diluted culture broth extract were applied to a Waters analytical column (YMC™) of 150 x 4.6 mm and eluted with a 1 mL/min flux of mobile phase [(60% water plus 0.1% trifluoroacetic acid)/40% acetonitrile], for 30 min, reaching 100% of acetonitrile in 10 min, held for 5 min, and then returned to the initial conditions (total time of the program= 50 min). Using these conditions HA eluted at approximately 24 min. Quantification of HA was carried out by comparison of that 24 min peak area against a calibration curve made with known amounts of purified HA (Cardoza et al., 2011). Each quantification was performed in duplicate.
2.4 Detection of trichothecene intermediates and aspinolides by gas chromatography-mass spectrometry (GC-MS)
We used GC-MS to detect other trichothecene intermediate compounds, e.g., trichodermol, trichodiene, isotrichodiol, 12,13-epoxytrichothec-9-ene (=EPT, trichothecene) (Cardoza et al., 2011), and other secondary metabolites also known to have antifungal activity, e.g., aspinolides. TP6.6 strain was grown in liquid yeast extract-peptone-dextrose (YEPD) cultures [5% glucose, 0.1% yeast extract, 0.1% peptone (Difco, Becton Dickinson)] (20 mL YEPD in 50 ml Erlenmeyer flasks) at 200 rpm and 28°C or 20°C, which are optimal and suboptimal temperatures, respectively, for trichothecene production. After 7 days, cultures were extracted with 3 mL of ethyl acetate. One μL of the extract was injected into a Hewlett Packard 6890 gas chromatograph fitted with a HP-5MS column (30 m, 0.25 mm, 0.25 µm) and a 5973-mass detector. The carrier gas was helium with a 20:1 split ratio and a 20 mL/min split flow. The column was held at 150°C for one minute following injection, heated to 280°C at 30°C/min and held for 3.6 min for a total run time of 9 min. Compound identifications were based on GC-MS comparisons with purified standards.
2.5 Fungal confrontation and antifungal assays on membranes
These assays were performed as described in previous reports (Malmierca et al., 2013) with some differences. For example, for the antifungal assays there were used only cellophane membranes (Shengzhou Pengyu Trading Co., Ltd) and pathogen´s growth was monitored until the third week of incubation at 28°C. Similarly, fungal confrontation assays were also monitored for three weeks, to see the long-term effects of the confrontation on the ability of the Trichoderma strains to overgrow the pathogens.
2.6 Fungal DNA extraction for genome sequencing
Spores (1 x 106 spores/mL) of the fungal strains isolated during the current study were grown in CM medium for 2 days at 28°C with shaking at 200 rpm. Mycelia were harvested by filtration, freeze dried, ground to a powder, and genomic DNAs were extracted using the DNeasy Plant Mini Kit (QIAGEN, Hilden, Germany). DNA purity and concentration were determined in a Nanodrop ND-1000 spectrophotometer.
2.7 Genome sequences and analysis
The genome sequence from strain TP6.6 was generated using a MiSeq Illumina platform (Illumina, Inc.), and was assembled with CLC NGS Cell v. 9.5 (Qiagen, Redwood City) as previously described (Proctor et al., 2018). For TP15.11 and TP19.13, their genome sequences were generated by Macrogen, Inc. (Seoul, Korea; https://dna.macrogen.com) using an Illumina platform, and sequence assemblies were generated using the SPAdes (v3.15.0) assembler software (Bankevich et al., 2012). The assembled but unannotated genome sequences were deposited into NCBI’s GenBank database with accession numbers JAMPTP000000000 (TP6.6), JAMQRS000000000 (TP15.11), and JAMQTF000000000 (TP19.13).
Assembled genomes were analyzed to detect secondary metabolite gene clusters with the prediction and annotation tool Augustus (Stanke et al., 2006; Hoff and Stanke, 2013), and Blast2GO software (Conesa et al., 2005). Then, the predicted genes/proteins were analyzed by Blast software using the OmicsBox v. 2.1.14 package (BioBam Informatics, https://www.biobam.com/omicsbox). Finally, the Augustus annotated genomes were analyzed with the antiSMASH software version 3.0.5 to detect putative secondary metabolite gene clusters (Medema et al., 2011).
2.8 Phylogenetic analysis
A Trichoderma species tree was inferred using amino acid sequences deduced from coding sequences of five housekeeping genes [act1 (encoding actin); fas1 (fatty acid synthase alpha subunit); rpb2 (RNA polymerase 2nd largest subunit), lcb2 (sphinganine palmitoyl transferase subunit 2); and tef1 (translation elongation factor 1-alpha)], which were retrieved from the genome sequences of TP6.6, TP15.11, and TP19.13 isolates. In this analysis, amino acid sequences of the five genes were also retrieved from previously generated genome sequences of 35 other Trichoderma species Gutiérrez et al. (2021). Finally, protein sequences were aligned using the software MUSCLE as implemented in MEGAX (Kumar et al., 2021), and then the alignments were concatenated using Sequence Matrix Software (Vaidya et al., 2011). The concatenated alignment was subjected to a maximum likelihood analysis (ML) using the software IQ-Tree, version 1.6.7. (Nguyen et al., 2015). Branch support was determined by bootstrap analysis using 1,000 pseudoreplicates. In addition, to assess the consistency of trees inferred from the five housekeeping genes, a gene concordance factor (GCF) analysis was performed as described by Minh et al., 2020. Thus, the percentage of individual protein trees containing each of the branches was calculated and included in the species tree. For the GCF analysis, a second concatenated-partitioned tree was constructed by selecting for each amino acid sequence alignment, the best-fit model of evolution deduced from the previous IQ-Tree analysis as described by Gutiérrez et al. (2021). This concatenated-partitioned alignment was also subjected to a ML analysis as implemented in IQ-Tree. The resulting IQ-tree file was used for GCF calculation based on Minh et al., 2020. In addition, an ML tree was inferred from tri5 coding sequences from selected Trichoderma isolates recovered from bean-field soils and previously described Trichoderma-tri5 sequences. Sequences alignment and ML analysis were performed as indicated above.
2.9 Microbiome analysis from soils
One of the soil samples that contained trichothecene-producing Trichoderma spp. was further used for a detailed microbiome analysis. This analysis was performed by Biome Makers Inc. (BECROP Smart Agriculture, Biome Makers, Europe. 47006 Valladolid, Spain) (https://biomemakers.com), through the use of the BeCrop® patented Technology. Four different samples were collected in sterile tubes from different points of the selected plot at two different time points (June-2019 and September-2019) at a depth of between 0 and 10 cm, which is a similar strategy to that followed to collect all samples used in this work. Soil samples were then analyzed by the Biome Makers laboratory.
2.9.1 DNA extraction, PCR amplification, and DNA sequencing
DNAs from these four samples was extracted using the Powerlyzer Powersoil Kit (Qiagen) by the BeCrop® Platform (patent publication number: WO2017096385, Biome Makers) (Becares and Fernández, 2017). For the identification of the fungal microbial communities associated with these bulk and rhizosphere soil samples, internal transcribed spacer (ITS) marker regions were amplified with Biome Makers custom primers (patent WO2017096385) (Gobbi et al., 2022). All PCR reactions were carried out following rutinary procedures, and libraries were prepared following a two-step PCR illumina protocol (Gobbi et al., 2019; Liao et al., 2019), and they were subsequently sequenced on an Illumina MiSeq device (Illumina) using 2 x 301 paired-end reads.
2.9.2 Bioinformatic processing
Primers were removed from paired end reads using Cutadapt (Martin, 2011). Then the trimmed reads were merged with a minimum overlapping of 100 nucleotides. Next, the sequences were quality filtered by Expected Error analysis (Edgar and Flyvbjerg, 2015) with a maximum value of 1.0. After quality pre-processing, reads having single nucleotide differences were iteratively clustered together to form Amplicon Sequencing Variants (ASVs) using Swarm (Mahé et al., 2021). De novo chimeras and remaining singletons were subsequently removed (Edgar et al., 2011). Finally, the ASVs were compared against Biome Makers´s internal reference database of amplicons using a global alignment with 97% identity to select the best hit; in cases of multiple best hits with identical qualities, the pipeline automatically adjusted the ASV result resolution to the nearest common ancestor of the hits’ taxonomies, which can decrease it to genus or family level. The reference database of amplicons was built using internal manually curated taxonomies from the latest version available of UNITE 8.3 for ITS sequences (Glöckner et al., 2017; Nilsson et al., 2019).
2.10 Growth of P. vulgaris, inoculation with Trichoderma spores, and infection with R. solani R43 and S. sclerotiorum S47
Bean seeds of variety “Riñón” harvested in 2019 and without visible disease symptoms were selected for this assay. The seeds were surface disinfested by washing with tap water, submerging for 3 minutes in a 1% bleach solution, and rinsing for 6 minutes with sterile distilled water as described previously (Mayo-Prieto et al., 2015).
Bean plants were grown in 1L pots, which were filled with sterilized (autoclaved for 1h, 120°C and a pressure of 1kg/cm2, for three consecutive days) peat substrate (Typ3, TYPical, Brill Substrate GmbH & Co) and surface irrigated with tap water (250 mL). Typ3 substrate has high air capacity and drainage, with a fine structure, pH 5.7, and elaborated from 65% white peat, and 35% black peat, and containing 0.5 kg/m3 NPK as fertilizer.
Fungal pathogens (R. solani R43 and S. sclerotiorum S47) were grown on 90 mm PDA Petri dishes by incubation at 25°C for 16 days in an incubation chamber. After this period, a liquid suspension of these fungal mycelia was prepared in sterilized distilled water as follows: PDA culture medium from 5 plates was mixed with 10 mL of water/plate, added to 1 L of distilled water and grounded to homogeneity. A suspension was prepared using PDA medium from 5 uninoculated plates to be used as a control. 50 mL of the homogenized pathogen suspension were added to each pot on the substrate surface, the inoculum was then covered by a thin layer of substrate to cover the pathogens inoculum and the pots were maintained for 8 days in the growth chamber at 25°C/16°C (16h/8h) in the dark.
Seeds were coated with a conidial suspension as described previously (Mayo-Prieto et al., 2015). Briefly, spore suspensions were prepared at a final concentration of 2 × 107 spores/mL in germination buffer (20 mM glucose, 20 mM KH2PO4). Bean seeds were surface sterilized (1% sodium hypochlorite for 3 min and distilled water for 6 min) and coated with the spore suspension of each Trichoderma isolate. The seeds were submerged in the spore suspension (45 seeds per 20 mL spores suspension) and they were dried in a flow chamber for 12 h. One inoculated “Riñón” bean, or one control bean without Trichoderma or without the pathogen, was placed in each pot, under the following treatments: 1- Control; 2- Δtri5.3; 3- TP6.6; 4- TP19.13. Pots were kept in a growth chamber for 45 days at 25°C (16 h)- light and 16 °C (8 h)- dark, 60% relative humidity. Pots were irrigated with tap water after the 9th day after sowing, and from that time, 2 irrigations were performed per week using 250 mL/pot. In addition, 250 mL/pot of a water dissolved nutritive solution (15-5-30/N-P-K, Hakaphos®, Compo Expert Spain) was applied on the 19th and 33rd day after sowing.
To avoid cross contamination, pots with and without the pathogen were placed on tables separated for 1 m.
The effect of the treatment with each Trichoderma strain on germination and plant growth, as well as on the plant response against R. solani and S. sclerotiorum were evaluated. Leaf samples were detached from four plants per treatment, infected or not with these pathogens for each Trichoderma strain, including controls without Trichoderma or without pathogens. Leaves were then maintained at -80°C for further analysis. Also, entire plants were washed to remove the potting mixture to detect any phenotypic differences in growth of aerial and below ground parts of the plants in the different treatments.
2.11 Statistical analysis of plant parameters
Means and statistical errors of the recorded data were calculated to evaluate bean germination and development for each treatment (three Trichoderma spp. and two pathogens). These bean parameters were analyzed by Levene’s test and compared by analysis of variance (two-ways ANOVA) for a completely randomized design including main effects of Trichoderma isolates (with three levels: Δtri5.3, TP6.6 and T19.13), and pathogens (with two levels: R. solani R43 and S. sclerotiorum S47). Finally, a post-hoc analysis of Duncan`s test was performed for each Trichoderma isolate and pathogen.
2.12 RNAseq and real-time quantitative PCR (qPCR) analysis
Leaves detached from plants of the different treatments were used for RNA extraction. Two batches of leaves were used per treatment, each with leaves from four different plants, which were independently processed, and constitute two biological replicates for each condition/treatment. Leaves were ground to a powder in a ceramic mortar, under liquid nitrogen. RNAs were extracted using TRIZOL reagent (Invitrogen) as described previously (Lindo et al., 2020). After the extraction procedure, RNA was treated with RNase-free DNase and purified through a Zymo-Spin column (Zymo Research). Total RNAs from each sample (=treatment) were quantified and the integrity was qualified by a NanoDrop (Thermo Fisher Scientific Inc.) and an Agilent 2100 Bioanalyzer (Agilent Technologies), respectively.
2.12.1 RNAseq analysis
Total RNAs with RNA integrity (RIN) values above 6.5 were sent to Macrogen, Inc. (https://dna.macrogen.com) for cDNA synthesis, library preparation, sequencing, and assembly. In this process, library construction and cDNAs sequencing were carried out using the TruSeq® Stranded mRNA LT Sample Prep kit on an Illumina platform. Trimmed reads were obtained by Trimmomatic (Bolger et al., 2014) software to remove adapter sequences, and were mapped to the reference Phaseolus vulgaris transcripts database, retrieved from NCBI repository (https://ftp.ncbi.nlm.nih.gov/genomes/genbank/plant/Phaseolus_vulgaris) (Latest assembly date 2022-04-06), with HISAT2 (Kim et al., 2019), splice-aware aligner. After the read mapping, Stringtie (Pertea et al., 2015) was used for transcript assembly. Expression profile was calculated for each sample and transcript/gene as reads count, FPKM (Fragments per kilobase of transcript per million mapped reads) and TPM (Transcripts per million reads).
DEG (Differentially Expressed Genes) analyses were performed on the nine designed comparison pairs. Thus, reads count data were normalized estimating size factors, and using them, the resulting count data were normalized with the Trimmed mean of M-values (TMM) method in edgeR library (Robinson et al., 2010). Then, a statistical test was performed with the normalized data using TMM count method for exact test (exactTest) in edgeR. Those transcripts showing a differential expression value/fc/>= 2 and a p-value <0.05 were considered as differentially expressed in the compared conditions.
For DEG analysis the Phaseolus vulgaris genes and proteins were functionally annotated using the application Blast2Go included in the software package OmicsBox (BioBam Informatics S.L).
2.12.2 qPCR analysis
This analysis was used to validate RNAseq data. RNA samples used for the qPCR analysis were the same as those used for RNAseq analysis. Thus, there were used samples from two biological replicates. cDNAs were synthesized separately from each replicate, and after the synthesis, these two cDNAs were mixed and used as a unique sample from each condition. qPCR reactions were carried out from these “mixed” samples as described previously (Lindo et al., 2020), and were analyzed by the 2-ΔΔCT method (Livak and Schmittgen, 2001), using the actin gene as a housekeeping internal control, and bean plants not inoculated with Trichoderma as the reference sample. The arithmetic average, and the standard deviation for three technical replicates were represented.
All oligonucleotides used were stable under the conditions used in the qPCR study as deduced from melting temperature study carried out for each oligonucleotide pair at the end of the 40 qPCR amplification cycles.
3 Results
3.1 Isolation of fungal strains from bean crop soils
Twenty-eight soil samples were collected from fields that were planted with beans at the time of sampling or during the previous cropping season. The fields have been managed using organic farming procedures and were located in seven municipalities within the PGI Alubia de La Bañeza-León, which is located in the northwestern Spanish province of León. The municipality names were as follows: Felechares de la Valdería (1 sample), Matalobos del Páramo (11 samples), Santibáñez de la Isla (3 samples), Urdiales del Páramo (2 samples), Villabúrbula (8 samples), Villamor de Órbigo (1 sample, Bustillo del Páramo (1 sample)), and Villarejo de Órbigo (1 sample) (Figures S1A, B).
The soil samples were processed as described in the methods section, by cultivating serial dilutions (10-2 to 10-4) in Rose Bengal-chloramphenicol agar medium, and incubated at 15°C for two weeks under natural light conditions to allow the growth of fungal colonies (Figure 1A). Colonies exhibiting Trichoderma-like morphology (Figure 1B) (i.e., green-spored colonies, growing as concentric sporulated green rings, and light pink-colored in the reverse side of the plate), were selected and identified as Trichoderma by analyzing their ITS sequences.

Figure 1 Isolation of Trichoderma strains from bean crop soils. (A) aspect of colonies isolated in Rose Bengal-Chloramphenicol medium used for fungal growth from dilutions 10-2 to 10-4 of the different bean crop soils analyzed in this work. (B) Two Trichoderma colonies are pointed to show the characteristic shape of most of the colonies from the species belonging to the genus Trichoderma that have been isolated in the current study.
3.2 Identification of Trichoderma species among all the fungal isolates
A total of 328 fungal colonies were selected from the Rose Bengal-Chloramphenicol plates and transferred to PDA medium. After incubation for 7 days at 28°C, 113 of these colonies were selected, based on their Trichoderma-like colony morphology (see Figure 1), for a preliminary identification using the DNA sequence of their ITS1 region. The identification was done by comparison of PCR-amplified sequences from each isolate with DNA sequences in NCBI’s nonredundant database. The results of this analysis indicated that 85 isolates were members of the genus Trichoderma and that the remaining isolates were members of other fungal genera, including Fusarium (n=17), Penicillium (3), Clonostachys (3), Mucor (2), Chaetomium (1), and Papulaspora (1) (Table S1).
3.3 Determination of species identity and selection of Trichoderma spp. with potential to produce trichothecenes
Of the 85 putative Trichoderma isolates, only TP6.6, TP6.13, TP15.11 and TP19.13 had ITS1 sequences that were more closely related to sequences from members of clade Brevicompactum than to members of other Trichoderma clades. Isolates TP6.6 and TP6.13 were both recovered from soil sample number 6 and had identical ITS1 sequences. Therefore, we selected TP6.6 for further analyses and did not examine TP6.13 further. The determination of species identity of TP6.6, TP15.11 and TP19.13 was done by phylogenetic analysis of the predicted amino acid sequences of five housekeeping genes (act1, fas1, rpb2, lcb2, and tef1) that were retrieved from the genome sequence data of the three isolates. The full-length protein sequences were aligned with the orthologous sequences from 35 Trichoderma species representing a wide breadth of the known phylogenetic diversity within the genus. In maximum likelihood trees inferred from sequences from four of five individual genes, the three bean-field isolates formed an exclusive and well-supported clade with the reference T. arundinaceum strain, IBT 40837. In a tree inferred from concatenated alignments of all five genes, the bean field isolates also formed an exclusive and well-supported (100% bootstrap value) with the reference T. arundinaceum strain (Figure 2). These findings indicate that isolates TP6.6, TP15.11 and TP19.13 are T. arundinaceum.

Figure 2 Trichoderma species tree inferred by maximum likelihood (ML) analysis of full-length amino acid sequences deduced from the full-length coding regions of five housekeeping genes. Numbers on branches are bootstrap values (blue type) based on 1000 pseudoreplicates and gene concordance factors (GCF, red type). Lineage names, as described previously (Kubicek et al., 2019; Gutiérrez et al., 2021), are indicated in red type to the right of the tree. Yellow rectangle highlights the positions of the three isolates recovered during the current study.
The rationale to identify isolates of the clade Brevicompactum was that previous studies indicated that most species in this lineage produce trichothecenes (Gutiérrez et al., 2021). Furthermore, according to the ITS1 sequence analysis, none of the Trichoderma isolates recovered in the current study belonged to the clades Psychrophila or Rubi, two other lineages in which most species produce trichothecenes (Chen et al., 2018; Gutiérrez et al., 2021). In addition, the ITS1 analysis indicated that none of the isolates belonged to species that produce trichothecenes but have not been assigned to a multispecies Trichoderma clade (e.g., T. albolutescens) (Ryu et al., 2017; Chen et al., 2021; Gutiérrez et al., 2021).
3.3.1 Detection and quantification of harzianum A (HA) by HPLC
HA production by isolates TP6.6, TP15.11 and TP19.13 was quantified in 48-h PDB cultures. The levels of HA produced were 46.0 μg/mL, 145.27 μg/mL, and 488.54 μg/mL, respectively. The previously well-characterized T. arundinaceum strain IBT 40837 (Ta37), which was used as a positive control, produced HA at 250.32 µg/mL (Figure 3A).

Figure 3 (A) Chromatograms from HPLC-UV analysis for determination of harzianum A production by T. arundinaceum IBT 40837 (Ta37) (wild-type strain); Δtri5.3, a trichothecene non-producing mutant; and TP19.13 one of the three Trichoderma sp. strains recovered in the present work and selected for further studies. Red arrow indicates the peak corresponding to HA. Ta37 and Δtri5.3 strains have been included for comparative purposes. (B) Chromatograms from GC-MS analysis for production of trichothecene intermediates (trichodermol) and aspinolides A and B from 7 days old culture supernatants of TP6.6 strain. Chromatograms in blue correspond to metabolites detected in cultures incubated at 28°C, and those in orange correspond to those incubated at 20°C. Note that a different scale was used in the lower right panel.
3.3.2 Analysis of strain TP6.6 by GC-MS to detect trichothecene biosynthetic intermediates and other secondary metabolites
Because isolate TP6.6 produced the lowest levels of HA of the three isolates examined, it was selected for further analysis by GC-MS to determine whether it produced other secondary metabolites. For this analysis, TP6.6 was grown for 7 days in YEPD medium at 20 or 28°C. When TP6.6 was grown at 28°C, it produced significant levels of trichodermol, a C4-hydroxylated precursor of HA. When grown at 20°C, TP6.6 produced a much lower level of trichodermol but higher levels of the polyketides aspinolides B and C (Figure 3B). In previous studies of T. arundinaceum, aspinolide production increased when HA production was blocked by inactivation of trichothecene biosynthetic genes or when conditions for HA production were not optimal (Malmierca et al., 2015; Izquierdo-Bueno et al., 2018; Cardoza et al., 2019; 2022).
3.4 Antifungal activity of the Trichoderma spp. isolated in the current study
The membrane and direct confrontation assays were both used to assess antifungal activity of bean-field isolates TP6.6 and TP19.13 against the phytopathogens R. solani and S. sclerotiorum. These pathogens were selected because they cause some of the most important diseases, e.g., root rots, affecting bean yield in the province of León. The previously characterized wild-type (IBT 40837) and trichothecene-nonproducing Δtri5.3 (=ΔT5.3) strains of T. arundinaceum were used as controls in the assays. Mutant strain ΔT5.3 was used to determine the importance of trichothecene production on antifungal activity of the strains used in this study.
In the confrontation assay, isolates TP6.6 and TP19.13 had overgrown R. solani after one week of incubation. After two and three weeks, TP6.6 and TP19.13 had completely parasitized R. solani, as we evident by R. solani no longer being visible. In contrast, the trichothecene-nonproducing mutant, Δtri5.3, had not overgrown R. solani even after three weeks (Figure 4). Also in the confrontation assay, TP6.6 and TP19.13 overgrew S. sclerotiorum but did so more slowly than with R. solani. That is, there was no apparent overgrowth after one week, but there was after two weeks (Figure 4). In addition, TP6.6 overgrew S. sclerotiorum slightly more rapidly than TP19.13. Δtri5.3 mutant lost this ability and did not overgrow the S. sclerotiorum colony after three weeks of growth.
Figure 4 Upper panels. Direct confrontation assays of Trichoderma strains, Δtri5.3 (= ΔT5.3), TP6.6 and TP19.13, versus the pathogens R. solani R43 (Rs) (first row), or S. sclerotiorum S47 (Ss) (second row). Plates were incubated for one (A), two (B), or three weeks (C). Control plates with the pathogens without Trichoderma are included in the left column. In all confrontations pathogen´s plugs are located at the right and Trichoderma plugs are located at the left of the plates. Lower panels. Cellophane membrane assays to analyze the antifungal activity of the same Trichoderma strains indicated above against Rs (third row) and Ss (forth row). Plates were incubated for one (A) or two (B) weeks after placement of the pathogen plug. Control plates with the pathogens grown without Trichoderma metabolites are included at the left column. Note that control plates were incubated in the same conditions as the plates where the direct confrontation or the cellophane membrane assays were performed.
The results of the membrane assay with R. solani were comparable to those of the confrontation assay in that both TP6.6 and TP19.13 almost completely inhibited the growth of R. solani after one and two weeks of incubation, while mutant Δtri5.3 caused markedly lower levels of inhibition. In contrast, all three Trichoderma strains almost completely inhibited growth of S. sclerotiorum at both time points (Figure 4).
Together, the results of the confrontation and membrane assays indicate that both bean-field isolates, TP6.6 and TP19.13, have strong antifungal activity against the two phytopathogens tested. The reduced antifungal activity of the trichothecene-nonproducing mutant, Δtri5.3, against R. solani in both assays indicates that HA production has an important role in the activity against R. solani. In contrast, the effects on growth of S. sclerotiorum by the trichothecene-nonproducing mutant Δtri5.3 versus trichothecene-producing bean-field isolates differed in the confrontation and membrane assays. In the confrontation assay, Δtri5.3 did not affect the growth of S. sclerotiorum in the same way as the bean-field isolates, but in the membrane assay, Δtri5.3 had the same inhibitory effect on the growth of S. sclerotiorum as the bean-files isolates, indicating that in membrane assay other metabolites produced by Δtri5.3, different from HA, are responsible for that antifungal activity against S. sclerotiorum.
3.5 Analysis of trichothecene biosynthetic loci in bean-field isolates
Genome sequences were also used to examine the trichothecene biosynthetic loci. A summary of the main features found in the genome sequences of the bean-field isolates TP6.6, TP15.11 and TP19.13 are shown in Table 1. Analysis of the sequences indicated that the three isolates had the three trichothecene biosynthetic loci previously described in the reference T. arundinaceum strain IBT 40837. The three loci are the tri5 locus, large tri cluster, and the small tri cluster (Figure 5). The order and orientation of genes within the loci were the same in the three bean-field isolates and strain IBT 40837. In addition, a heretofore unrecognized pseudogenized copy of the trichothecene regulatory gene tri6 was found in the small tri cluster locus. Reanalysis of previously analyzed genome sequences indicated that a tri6 pseudogene (=6Ψ) was present at at the genomic location in other HA-producing Trichoderma species (e.g., T. turrialbense and T. protrudens) (data not shown).

Table 1 Summary of genome sequence assembly statistics for the three strains of T. arundinaceum isolated during the current study.

Figure 5 Trichothecene biosynthetic genes (tri) in the genomes of the three Trichoderma strains isolated in the current study. Trichoderma arundinaceum IBT40837 was included for comparative purposes. Numbers inside arrows indicate the tri gene illustrated, e.g., 5 corresponds to tri5 gene. Different arrow colors indicate different gene functions as shown at the bottom of the figure. Ψ corresponds to a tri6-pseudogene.
3.6 tri5 phylogenetic analysis
An ML analysis was performed to assess the phylogenetic relationships of tri5 homologs from the three bean-field isolates to homologs from 29 Trichoderma species (Table S2) (Gutiérrez et al., 2021). In the resulting ML tree, the tri5 orthologs from TP6.6, TP15.11 and TP19.13 formed an exclusive and well-supported clade (bootstrap value 100%) with the ortholog from the T. arundinaceum reference strain IBT 40837 (Figure 6), providing further evidence for the close relationship of the bean-field isolates and the reference strain.

Figure 6 Phylogenetic tree inferred by maximum likelihood analysis of full-length exon sequences of tri5 from TP6.6, TP15.11 and TP19.13 strains, and other 30 Trichoderma species. Numbers on each branch (blue type) are bootstrap values based on 1000 pseudoreplicates. Yellow rectangle points to the tri5 from the three isolates selected in the current study.
3.7 Microbiome analysis
A DNA-sequencing-based microbiome approach was used to determine if the Trichoderma trichothecene-producer strains isolated following traditional microbiological procedures can be also detected following that strategy. For this analysis, DNA libraries were prepared from four soil samples collected from plot number 6, the same location from which T. arundinaceum isolate TP6.6 was recovered. From these four libraries, a total of 1,944 fungal ITS1 sequences were generated and then used as an in-house database for a BLASTn analysis with the ITS1 sequence from T. arundinaceum IBT 40837 serving as the query. The ITS1 sequences showing the highest hit to the IBT 40837 sequence were then used as queries in BLASTn analysis with another in-house genome sequence database, which included genome sequences from all species in the Brevicompactum, Psychrophila and Rubi clades and from the species T. albolutescens (i.e., all trichothecene-producing species of Trichoderma). This analysis identified three ITS1 sequences, 6.6-01M-82e2, 6.6-014-82e2, and 6.6-01I-538b, which were most closely related to ITS1 sequences from members of clade Brevicompactum. An ML tree was then inferred from an alignment of 6.6-01M-82e2, 6.6-014-82e2, and 6.6-01I-538b, ITS1 sequences from isolates TP6.6, TP15.11, and TP19.13, all publicly available ITS1 sequences from species in clade Brevicompactum, and 12 additional ITS1 sequences from our microbiome analysis that were similar but not identical to ITS1 sequences from members of clade Brevicompactum. In the resulting tree, sequences 6.6-01M-82e2, 6.6-014-82e2, and 6.6-01I-538b formed an exclusive and well-supported clade (bootstrap value 91) with the ITS1 sequences from T. arundinaceum IBT 40837 and the bean-field isolates TP6.6, TP15.11 and TP19.13 (Figure 7). These data indicated that T. arundinaceum strains previously selected from soils by classical microbiological methods were also detected by microbiomic approaches.

Figure 7 Phylogenetic tree inferred by maximum likelihood analysis of selected ITS1 sequence (193 bp) from amplicons retrieved from the microbiome analysis (black type, 6.6-01#) and Trichoderma species in the Brevicompactum clade (blue type sequences), The amplicon sequences selected for this analysis were those with the highest scores in BLASTn analysis in which the ITS1 sequence from the T. arundinaceum reference strain IBT 40837 was queried against all ITS1 amplicon sequences derived from four soil samples collected from Plot 6. Numbers near each branch (blue type) are bootstrap values based on 1,000 pseudoreplicates. Yellow rectangle denotes sequences of the three T. arundinaceum strains isolated in the current study and the reference strain IBT 40837. Green rectangles denote amplicon sequences that are identical to ITS1 from reference strain IBT 40837.
3.8 Detection of biosynthetic gene clusters (BGC) putatively involved in the synthesis of secondary metabolites from the genome sequences of strains TP6.6, TP15.11 and TP19.13
Genome sequence data from bean-field isolates TP6.6, TP15.11 and TP19.13 were subjected to antiSMASH analysis to identify the secondary metabolite biosynthetic gene clusters (BGCs) present in the three genomes (Medema et al., 2011). The results of the analysis indicated that the number of BGCs as well as the numbers of PKS, NRPS, Hybrid PKS-NRPS and terpene synthase genes in the three bean-field isolates were similar to those in the reference T. arundinaceum strains IBT 40837, which is predicted to have 50 BGCs; 23 PKS genes, 25 NRPS genes, 5 hybrid PKS-NRPS genes, and 10 terpene synthase genes (Table 2).

Table 2 Number of biosynthetic gene clusters (BGC), PKS, NRPS, hybrid PKS-NRPS, and terpene synthase encoding genes found in the genomes of the three isolates selected in the current study, as deduced from Augustus and antiSMASH analyses.
3.9 Effect of HA production on the germination and growth of bean plants in the presence of the pathogens R. solani and S. sclerotiorum
Isolates TP6.6 and TP19.13 were selected for this analysis because they produced the lowest and the highest, respectively, levels of HA among the three T. arundinaceum bean-field isolates recovered in the study. Bean seeds from the “Riñón” variety were coated with spores of T. arundinaceum TP6.6 or TP19.13 and then sown in pots containing soil infested with R. solani and S. sclerotiorum. The next parameters were analyzed: 1. Germination- In the soil that was not infested with the plant pathogens, bean seeds coated with either T. arundinaceum isolate had a higher germination rate than the uncoated control seeds only at 9 and 12 days after sowing but not at 18 or 25 days (Figure 8A; Table S3). In contrast, in soils that were infested with the plant pathogens, differences between the presence of pathogen and Trichoderma were only statistically significant for conditions where S. sclerotiorum was present in the substrate at 25 days after sowing. In this condition a lower germination rate was observed for seeds inoculated with Δtri5.3 and grown in substrate amended with this pathogen, compared to the control with only the pathogen and also to the seeds inoculated with the TP6.6 or TP19.13 (HA-producers) grown in the same conditions, i.e., in substrate amended with S47 (Figure 8B; Table S3). These results were not observed when the pathogen R. solani was used to perform the same analyses (Figure 8B). Finally, the presence of the pathogens without Trichoderma did not significantly affect germination (data not shown). 2. Growth- Plant growth was assessed using separate dry weight measurements of aerial plant parts and the root system. Growth of aerial plant parts was significantly greater in the TP6.6-inoculation treatment compared to Δtri5.3-inoculation treatments (Figure 9A; Table S4). Furthermore, root system growth was higher in plants grown in R. solani-infested soil compared to uninfested soil. However, this increased root growth in R. solani-infested soil was reduced by the presence of any of the T. arundinaceum isolates analyzed in this work. Root system growth was not affected in soil infested with S. sclerotiorum alone. However, the growth was increased in the S. sclerotiorum-TP6.6 co-inoculation treatment compared to the S. sclerotiorum-alone, S. sclerotiorum-TP19.13 co-inoculated, or S. sclerotiorum-Δtri5.3 treatments, but these differences were not statistically significant (Figure 9B; Table S4; Figure S2).

Figure 8 Mean comparison (Duncan’s multiple range test) for: (A) bean seed germination without any Trichoderma treatment (Control) and coated with the three Trichoderma strains used in this study (ΔT5.3, TP6.6, and TP19.13), incubated for 9 to 25 days after sowing, and (B) germination of bean seeds after 25 days from sown, using as source of variation the Pathogen [R. solani R43 (=R43) and S. sclerotiorum (=S47)], without any Trichoderma treatment (control) and coated with the three Trichoderma strains used in this study (ΔT5.3, TP6.6, and TP19.13). CR43 and CS47 correspond to seeds grown in substrate infected with R. solani R43 and S. sclerotiorum S47, respectively. CΔT5.3, CTP6.6, and CTP19.13= seeds inoculated with spores of ΔT5.3, TP6.6, and TP19.13, respectively, which were grown in substrate without previous pathogen inoculation. R43+# and S47+#= seeds coated with the Trichoderma strain indicated on each name (#=ΔT5.3, TP6.6, or TP19.13) and grown in a substrate previously infected with R. solani R43 and S. sclerotiorum S47, respectively. Different lowercase letters (a, b) above the bars indicate statistically significant differences between the analyzed treatments (p<0.05). ΔT5.3= Δtri5.3.

Figure 9 Mean comparison (Duncan’s multiple range test) of dry weight (DW) of 45 days old bean plants. (A) Evaluation of DW of aerial parts from plants grown from seeds without any Trichoderma treatment (Control) and coated with the three Trichoderma strains used in this study (ΔT5.3, TP6.6, and TP19.13). (B) Analysis of DW of root system using as source of variation the pathogen x Trichoderma interaction. Within (A, B), different letters above bars indicate significant differences (p<0.05). For the description of the different treatments (x-axis) see legend to Figure 8. ΔT5.3= Δtri5.3.
3.10 Effect of trichothecene producing Trichoderma strains on the bean transcriptome
Leaves detached from plants under the different treatments were used in the present study and processed as described in the Material and Methods section. A total of 1.238,9 million reads were obtained, after trimming and processing the raw reads (Table S5). A differentially expressed gene (DEG) analysis was performed to determine the differential expression of bean genes in the conditions analyzed. In this analysis, even though leaves from plants treated with the three mentioned strains were used for mRNA isolation, only TP19.13 and Δtri5.3 strains were analyzed by RNAseq, based on the higher level of production of HA shown by TP19.13 compared to TP6.6. However, mRNA from plants treated with the strain TP6.6 were further included in the qPCR analysis, together with those from plants treated with TP19.13 and Δtri5.3, in order to validate the RNAseq results.
Data of the whole transcriptome analysis, including the 9 comparisons analyzed in the present work, indicated that among the 32,720 transcripts detected in the Phaseolus vulgaris genome (assembly PhaVulg1_0) (https://ftp.ncbi.nlm.nih.gov/genomes/all/GCF/000/499/845/GCF_000499845.1_PhaVulg1_0/), 14,942 were differentially expressed (Table S6; Figure S3). However, our analysis focused on defense-related genes and also on genes related to hormone biosynthesis, and to hormone signaling pathways, which could be also related to plant defense response. To carry out this study, 15 genes were initially selected: CHS.3 (involved in phenylpropanoid biosynthesis); CPRD14.4 and CPRD14.3 (stress response); Lox2.3 and Lox1.3 (biosynthesis of antimicrobials and oxylipins- important as defense signaling molecules); AOS.4 (allene oxide synthase- oxylipins pathway); LTP2.1, MMP2.2, TSI-1.2, PR1.2 and PR16a (pathogenesis related genes); GTSa.1 (oxidative stress); Ch5b.3 (endochitinase precursor- pathogenesis related gene); ERF5 (ethylene-responsive transcription factor 5- ethylene signaling pathway); and SIP.3 (Syringolide induced protein B13.1.9- defense response) (Table S7).
Data from RNAseq analysis were later validated by qPCR, using custom primer pairs designed for each of the analyzed genes, whose amplification efficiencies range between 85.4% and 114% (Table S8). This analysis also included the data from TP6.6 strain, which was not used in the RNAseq analysis. The actin gene was used as a housekeeping internal control (=reference gene), and bean plants not inoculated with Trichoderma as the reference sample.
Expression of many of the analyzed defense-related genes was affected by the production of HA, since the expression of these genes was significantly different in plants inoculated with the trichothecene producing strains, TP6.6 and TP19.13, in comparison to the trichothecene non-producing mutant Δtri5.3 (Figure 10). In addition, when the qPCR results were compared to those from the RNAseq analysis, a correlation in the tendencies of both groups of data was observed (Figure 10), even though the absolute values were different, which should be expected due to great methodology differences in the obtention of the data between those procedures. Thus, combining results from both analyses (qPCR and RNAseq), among the 15 genes analyzed by qPCR, only Lox2.3 and Lox1.3 (biosynthesis of oxylipins) were significantly downregulated in plants inoculated with the two HA producers used in this analysis (TP19.13 and TP6.6) versus plants inoculated with the HA-non producing mutant (ΔT5.3); and three genes (LPT2.1, PR16a-pathogenesis related-, and SIP3- related to defense response-) were significantly upregulated in the same comparison as above (Figure 10).

Figure 10 (A) Relative expression level of 15 defense-related genes selected for the present study as deduced from the RNAseq analysis. Relative expression was inferred as the ratio of the normalized expression level (TMM) of each gene versus the actin. The values were calculated as the average and standard deviation of two biological replicates. (B) qPCR analysis to determine relative expression of the same 15 defense-related genes as above. Arithmetic average and standard deviation data from three technical replicates were represented. Analysis was performed by the 2-ΔΔCT method (Livak and Schmittgen, 2001), using the actin gene as a housekeeping internal control, and bean plants not inoculated with Trichoderma as the reference sample.
We also analyzed the RNAseq data for differential expression of other defense-related genes, including genes encoding for enzymes involved in the biosynthesis of ethylene, abscisic acid (ABA), phytoalexins, genes related with oxidative stress [reactive oxygen species (ROS), H2O2, glutathione], genes related with cell wall biosynthesis, pathogenesis related (PR), and related to alternative secondary metabolite biosynthetic genes. In this analysis, genes showing expression ratios >=2 or <=0.5, with p values <=0.05 between the two compared samples were considered.
As result, the comparison with the greatest differences in expression was TP19.13 vs. Δtri5.3; 31 genes were upregulated and 31 were downregulated (Figure 11). This indicates that production of HA by TP19.13 had a marked effect on the plant defense response. Furthermore, in all conditions that included R. solani-infested soil, the number of differentially expressed genes was lower than in the treatments with uninfested soil or S. sclerotiorum-infested soil. Regarding the differences observed between the different groups of genes, in the absence of a plant pathogen, inoculation with Δtri5.3 resulted in upregulation of genes related with jasmonate, oxylipins, and ethylene signaling pathways versus inoculation with TP19.13. However, the opposite was observed in treatments with S. sclerotiorum (Figure 11).

Figure 11 Representation of the number of genes up- or down-regulated within the different categories analyzed (upregulated: >=2, downregulated: <=-2). Comparisons represented are as follows: ΔT5/CC (plants inoculated with the strain ΔT5.3 versus non-inoculated plants), 19/CC (plants inoculated with the strain TP19.13 versus non-inoculated plants), 19/ΔT5 (plants inoculated with TP19.13 versus plants inoculated with ΔT5.3), 19R/CR (plants inoculated with T19.13 versus non-inoculated plants, both grown in the substrate infected with the pathogen R. solani R43), 19R/ΔT5R (plants inoculated with T19.13 versus plants inoculated with ΔT5.3, both grown in substrate infected with R. solani R43), ΔT5S/CS (plants inoculated with ΔT5.3 versus non-inoculated plants, both grown in substrate infected with S. sclerotiorum S47), 19S/CS (plants inoculated with TP19.13 versus non-inoculated plants, both grown in substrate infected with S. sclerotiorum S47), and 19S/ΔT5S (plants inoculated with TP19.13 versus plants inoculated with ΔT5.3, both grown in substrates amended with S. sclerotiorum S47). Sixty-four genes were selected for this analysis (Table 3). The genes were grouped based on to their blast annotated function as indicated at the bottom part of the figure. ΔT5= ΔT5.3= Δtri5.3.
Finally, regarding the individual genes analyzed by RNAseq, four chitinases-encoding genes were up-regulated by TP19.13 versus Δtri5.3 (gene codes in Table 3: PHAVU_009G116300g, _009G1165001g, _003G158500g, and _001G046400g), and only one chitinase was upregulated at a higher level by Δtri5.3 versus TP19.13 (gene code in Table 3: PHAVU_011G167000g). The expression pattern in the ethylene-related genes was variable, with some genes upregulated in plants inoculated with Δtri5.3, and others upregulated in plants inoculated with TP19.13.
4 Discussion
The effect of trichothecene production on plants has most often been analyzed related to plant pathogenic fungi, particularly Fusarium species. Some trichothecene analogs are phytotoxic and serve a critical role in virulence in certain plant-pathogen interactions (Harris et al., 1999). The first report regarding production of trichothecenes in Trichoderma species, describes production of HA in an unidentified Hypocrea strain, and correlates trichothecene with toxicity against human tumor cell lines (Lee et al., 2005). Today, trichothecene production has been reported in at least 13 Trichoderma species (Sun et al., 2016; Gutiérrez et al., 2021). These species have been isolated from diverse substrates, ranging from plant endophytes to soils from multiple countries and environments (Nielsen et al., 2005; Degenkolb et al., 2008; Jaklitsch, 2011; Jaklitsch and Voglmayr, 2015). However, to our knowledge, no attempts have been made to study the diversity of trichothecene-producing Trichoderma species in crop soils or their importance as indigenous microbes in the interaction with crops. Since the description of trichothecene production, Trichoderma species producing these compounds have been considered as strains outside the groups with biotechnological interest (Degenkolb et al., 2008). This rationale was based in the knowledge of the toxicity exhibited by most of the trichothecenes studied until now, in fact some Trichoderma trichothecenes, for example trichodermin, have also been described as highly toxic for plants (Tijerino et al., 2011).
However, works carried out in the last decade have revealed that some Trichoderma species produce trichothecenes that do not have phytotoxicity, e.g., T. arundinaceum and T. albolutescens (Ryu et al., 2017; Gutiérrez et al., 2020). In the opposite, trichothecenes produced by these species exhibit stimulatory effects of the plant defense response against diverse plant diseases (Malmierca et al., 2015; Malmierca et al., 2016; Ryu et al., 2017). Thus, this change in the paradigm considering trichothecenes as mycotoxins with pernicious effects on plant health, has driven the objectives of this work.
The three HA-producing T. arundinaceum strains recovered in the current study constituted 4.7% of the Trichoderma isolates recovered from the 28 soil samples processed. In general, the number of Trichoderma isolates recovered from each sample was low. Regardless, strains TP6.6, TP15.11 and TP19.13 constituted 33% (n=3), 33% (n=3) and 8% (n =12) of the total fungal isolates recovered from their respective samples. Previous studies have reported the isolation of Trichoderma strains from bean crops (Lopes et al., 2012; Mayo-Prieto et al., 2020a). However, these studies were not focused on the isolation of Trichoderma strains able to produce trichothecenes. Interestingly, the traditional isolation procedure (=culture, genome sequencing, phylogenetic analysis) and the microbiome approach both detected T. arundinaceum in soil from the plot number 6.
Genome sequences of the three T. arundinaceum isolates indicated a very high degree of similarity with the genome sequence of T. arundinaceum IBT 40837, which is an indigenous strain isolated in Iran. This indicates similar genetic profiles despite their so distant geographical origins. The analysis in these isolates of the genomic regions including the genes involved in trichothecene biosynthesis (=tri genes) revealed the presence of all genes previously described for strain IBT 40837 (Proctor et al., 2018; Proctor et al., 2020) with an almost total degree of synteny, with just minor differences in the length of the intergenic regions. Furthermore, a new feature was detected, corresponding to a tri6 degenerated copy (6Ψ) that was detected in the intergenic region between tri18 and tri23. This degenerated tri6 was detected in all Trichoderma strains producing HA, e.g., T. arundinaceum IBT 40837, T. protrudens and T. turrialbense.
Consistent with the presence of the three tri loci in their genome sequences, the three selected isolates produced HA. In addition, a more detailed GC-MS based metabolomic analysis was carried out to detect intermediates of the HA biosynthesis, and other secondary metabolites. Data revealed production of trichodermol, an intermediate in the biosynthesis of HA that was previously reported in cultures of the reference strain T. arundinaceum IBT 40837 (Lindo et al., 2018). In addition, aspinolides B and C were found in T. arundinaceum TP6.6, but only when grown at 20°C. Production of aspinolides by T. arundinaceum was already reported (Malmierca et al., 2015; Izquierdo-Bueno et al., 2018; Cardoza et al., 2022), and their production together with other additional aspinolides was observed mainly when production of HA was partial or totally blocked (Malmierca et al., 2015; Izquierdo-Bueno et al., 2018). In addition, data observed in the present article also support the hypothesis that production of aspinolides is stimulated when T. aundinaceum was grown at suboptimal conditions, e.g., 20°C, as was previously described for IBT 40837 strain (Cardoza et al., 2022). Furthermore, in correlation with their ability to produce HA, the three isolates also shown a significant antifungal activity against the bean pathogens R. solani and S. sclerotiorum, in comparison to the HA non-producer mutant Δtri5.3, which agrees with previous reports indicating the importance of HA production on the antifungal activity of the producer Trichoderma isolates (Malmierca et al., 2013).
Regarding plant growth, an especially significant positive effect on growth was observed in the growth of aerial parts, but only in the presence of TP6.6. Growth of root system was also increased in the presence of the same isolate but only in plants grown in substrate infected with S. sclerotiorum S47. Positive effects of Trichoderma inoculation on bean germination and growth had been already reported (Pereira et al., 2014; Mayo-Prieto et al., 2015). However, in the present case a great difference between both HA producers (TP19.13 and TP6.6) isolated in this work was observed, which would indicate that even though these isolates share a common origin some differences between them, e.g., level of HA production, would give also to different plant-responses. Therefore, for the use of T. arundinaceum isolates in biocontrol, strain selection should be essential to maximize their positive effects.
On the other hand, the absence of obvious “root rot” symptoms observed in the present work in plants infected with R. solani and S. sclerotiorum, could be attributed to the differences in temperature, substrate, humidity, etc, used in the incubation chambers to perform the current study, in comparison versus the conditions existing in the natural field environment. Thus, most likely the variations in environmental conditions might have been able to negatively influence the appearance of pathogenicity symptoms caused by R. solani and S. sclerotiorum
Furthermore, in order to characterize the importance of HA production to Trichoderma-bean interactions, a transcriptomic study was performed, which was later validated with a qPCR partial analysis. Thus, production of trichothecenes drastically affected expression of genes related to plant defense, being the highest differences observed when compared TP19.13 vs Δtri5.3 inoculated plants, which would indicate the remarkable effect exerted by trichothecenes in the bean defense response. In this sense TP19.13 down-regulated genes related to jasmonate, oxylipins, and ethylene signaling pathways in comparison versus plants inoculated with Δtri5.3, in both cases without pathogen. However, an opposite effect was observed when S. sclerotiorum was present. There are multiple reports on the effect of Trichoderma isolates on the transcriptome of bean plants, particularly related to effects on defense related genes (Lehtonen et al., 2008; Guerrero-González et al., 2011; Pereira et al., 2014; Mayo-Prieto et al., 2015; Mayo-Prieto et al., 2016). However, the results from the current study provide evidence that trichothecene production can impact in vivo on the transcription of defense related genes in P. vulgaris.
Four chitinase-encoding genes were upregulated by TP19.13 versus Δtri5.3, and only one chitinase was positively regulated at a higher level by Δtri5.3, which suggest that HA might induce plant-defense response, in agreement with previous reports (Malmierca et al., 2012; Malmierca et al., 2013), and also emphasizes the role of chitinases in the plant-defense response (Lehtonen et al., 2008; Lopes et al., 2012). However, the pattern of expression of other groups of genes was diverse, e.g., ethylene-related genes, with some genes up-regulated in plants inoculated with Δtri5.3, and others in plants with TP19.13.
In conclusion, the procedures used in the present study to recover trichothecene-producing Trichoderma strains from bean field soils, which were initially based on classical microbiological methods, and further supported by genomic, metabolomic and transciptomic analyses, have been successful. All isolates of T. arundinaceum recovered in this study produced HA, in addition to aspinolides, the latter being secondary metabolites with bioactivities similar to those of HA. The three bean-field isolates of T. arundinaceum exhibit different levels of HA production. Despite that they all exhibited a strong in vitro antifungal effect against R. solani and S. sclerotiorum. In addition, T. arundinaceum strains isolated from bean fields stimulated bean seed germination and promote growth of above-ground parts of the bean plants, the latter only in the case inoculated with isolate TP6.6. Finally, trichothecene production by T. arundinaceum affected expression of plant defense-related genes, including up-regulation of plant hormone-signaling related genes in the presence of S. sclerotiorum and of most of the chitinase encoding genes analyzed. Results included in the current study show the potential for Trichoderma isolates that produce non-phytotoxic trichothecenes to induce plant defenses without negatively affecting germination and development.
Data availability statement
The original contributions presented in the study are publicly available. The assembled Whole Genome Shotgun sequences have been deposited at DDBJ/ENA/GenBank under the accession numbers JAMPTP000000000 (for TP6.6), JAMQRS000000000 (TP15.11), and JAMQTF000000000 (TP19.13).
Author contributions
SG and PAC conceived and designed the research. REC performed all genetic experiments and quantified harzianum A production. SPM conducted the GC-MS analyses to identify and quantify the metabolites produced by the different isolates and contributed to the final correction of the manuscript. SM-P, PAC, ÁR-G, AL, GC-H, and MPC performed the fungal-plant in vivo assays, and analyzed the results obtained from these experiments. NM-R conducted qPCR experiments and analyzed transcriptomic data. RHP and SG conducted the sequence and phylogenetic analysis. SG, PAC, and RHP wrote the manuscript. All authors read and approved the manuscript.
Funding
This work is a part of the Spanish I+D+i Grants RTI2018-099600-B-I00 and PID2021-123874OB-I00, financed by the MCIN/ AEI/10.13039/501100011033. GC-H was awarded with a Grant from the Ministry of Education, Culture, and Sport (Spain) (Grant number FPU15/04681). NM-R was awarded with a Grant from the Junta de Castilla y León (Spain) (ORDEN EDU/875/2021, July 13th, 2021).
Acknowledgments
We acknowledge to ecological farmers Gabriel Alegre and Juan Carlos García from AGRELE (“Agricultores y Ganaderos Ecológicos de León”) for their collaboration to collect the soil samples. Finally, we also acknowledge to José Álvarez and Paula Vales from the University of León, and Crystal Probyn, Amy McGovern, and Christine Poppe from the United States Department of Agriculture for their excellent technical assistance.
Conflict of interest
The authors declare that the research was conducted in the absence of any commercial or financial relationships that could be construed as a potential conflict of interest.
Publisher’s note
All claims expressed in this article are solely those of the authors and do not necessarily represent those of their affiliated organizations, or those of the publisher, the editors and the reviewers. Any product that may be evaluated in this article, or claim that may be made by its manufacturer, is not guaranteed or endorsed by the publisher.
Author disclaimer
Mention of trade names or commercial products in this publication is solely for the purpose of providing specific information and does not imply recommendation or endorsement by the U.S. Department of Agriculture. USDA is an equal opportunity provider and employer.
Supplementary material
The Supplementary Material for this article can be found online at: https://www.frontiersin.org/articles/10.3389/fpls.2022.1005906/full#supplementary-material
References
Bankevich, A., Nurk, S., Antipov, D., Gurevich, A. A., Dvorkin, M., Kulikov, A. S., et al. (2012). SPAdes: A new venome assembly algorithm and its applications to single-cell sequencing. J. Comput. Biol. 19, 455–477. doi: 10.1089/cmb.2012.0021
Becares, A., Fernández, A. F. (2017). Microbiome based identification, monitoring and enhancement of fermentation processes and products. International Patent WO 2017/096385 A1.
Benitez, T., Rincón, A. M., Limón, M. C., Codón, A. C. (2004). Biocontrol mechanisms of Trichoderma strains. Int. Microbiol. 7 (4), 249–260.
Bolger, A. M., Lohse, M., Usadel, B. (2014). Trimmomatic: A flexible trimmer for illumina sequence data. Bioinformatics 30, 2114–2120. doi: 10.1093/bioinformatics/btu170
Cardoza, R. E., Malmierca, M. G., Hermosa, M. R., Alexander, N. J., McCormick, S. P., Proctor, R. H., et al. (2011). Identification of loci and functional characterization of trichothecene biosynthesis genes in filamentous fungi of the genus Trichoderma. Appl. Environm. Microbiol. 77, 4867–4877. doi: 10.1128/AEM.00595-11
Cardoza, R. E., McCormick, S. P., Izquierdo-Bueno, I., Martínez-Reyes, N., Lindo, L., Brown, D. W., et al. (2022). Identification of polyketide synthase genes required for aspinolide biosynthesis in Trichoderma arundinaceum. Appl. Microbiol. Biotechnol. 106, 7153–7171. doi: 10.1007/s00253-12182-9
Cardoza, R. E., McCormick, S. P., Lindo, L., Kim, H.-S., Olivera, E. R., Nelson, D. R., et al. (2019). A cytochrome P450 monooxygenase gene required for biosynthesis of the trichothecene toxin harzianum a in Trichoderma. Appl. Microbiol. Biotechnol. 103, 8087–8103. doi: 10.1007/s00253-019-10047-2
Casquero, P. A., Lema, M., Santalla, M., De Ron, A. M. (2006). Performance of common bean (Phaseolus vulgaris L.) landraces from Spain in the Atlantic and Mediterranean environments. Genet. Resour. Crop Evol. 53, 1021–1032. doi: 10.1007/s10722-004-7794-1
Chen, B., Li, E., Liu, L., Liao, M., Zhu, Z., Zhuang, W., et al. (2018). Botryane sesquiterpenoids, cyclopentadepsipeptides, xanthones, and trichothecenes from Trichoderma oligosporum. Planta Med. 84, 1055–1063. doi: 10.1055/a-0593-6030
Chen, H., Mao, L., Zhao, N., Xia, C., Liu, J., Kubicek, C. P., et al. (2021). Verification of TRI3 acetylation of trichodermol to trichodermin in the plant endophyte Trichoderma taxi. Front. Microbiol. 12. doi: 10.3389/fmicb.2021.731425
Conesa, A., Götz, S., García-Gómez, J. M., Terol, J., Talón, M., Robles, M. (2005). Blast2GO: A universal tool for annotation, visualization and analysis in functional genomics research. Bioinformatics 21, 3674–3676. doi: 10.1093/bioinformatics/bit610
Cundliffe, E., Cannon, M., Davies, J. (1974). Mechanism of inhibition of eukaryotic protein synthesis by trichothecene fungal toxins. Proc. Nat. Acad. Sci. U.S.A. 71 (1), 30–34. doi: 10.1073/pnas.71.1.30
Degenkolb, T., Dieckmann, R., Nielsen, K. F., Gräfenhan, T., Theis, C., Zafari, D., et al. (2008). The Trichoderma brevicompactum clade: a separate lineage with new species, new peptaibiotics, and mycotoxins. Mycol. Prog. 7, 177–219. doi: 10.1007/s11557-008-0563-3
Desjardins, A. E. (2006). Fusarium mycotoxins: Chemistry, genetics and biology (St Paul: APS Press).
Edgar, R. C., Flyvbjerg, H. (2015). Error filtering, pair assembly and error correction for next-generation sequencing reads. Bioinformatics 31 (21), 3476–3482. doi: 10.1093/bioinformatics/btv401
Edgar, R. C., Haas, B. J., Clemente, J. C., Quince, C., Knight, R. (2011). UCHIME improves sensitivity and speed of chimera detection. Bioinformatics 27 (16), 2194–2200. doi: 10.1093/bioinformatics/btr381
Glöckner, F. O., Yilmaz, P., Quast, C., Gerken, J., Beccati, A., Ciuprina, A., et al. (2017). 25 years of serving the community with ribosomal RNA gene reference databases and tools. J. Biotechnol. 261, 169–176. doi: 10.1016/j.biotec.2017.06.1198
Gobbi, A., Acedo, A., Imam, B., Santini, R. G., Ortiz-Álvarez, R., Ellegaard-Jensen, L., et al. (2022). A global microbiome survery of vineyard soils highlights the microbial dimension of viticultural terroirs. Commun. Biol. 5, 241. doi: 10.1038/s42003-022-03202-5
Gobbi, A., Santini, R. G., Filippi, E., Ellegaard-Jensen, L., Jacobsen, C. S., Hansen, L. H. (2019). Quantitative and qualitative evaluation of the impact of the G2 enhancer, bead sizes and lysing tubes on the bacterial community composition during DNA extraction from recalcitrant soil core samples based on community sequencing and qPCR. PloS One 14, e0200979. doi: 10.1371/journal.pone.0200979
Goswami, J., Pandey, R. K., Tewari, J. P., Goswami, B. K. (2008). Management of root knot nematode on tomato through application of fungal antagonists, Acremonium strictum and Trichoderma harzianum. J. Environ. Sci. Health 43, 237–240. doi: 10.1080/03601230701771164
Guerrero-González, M. L., Rodríguez-Kessler, M., Rodríguez-Guerra, R., González-Chavira, M., Simpson, J., Sanchez, F., et al. (2011). Differential expression of Phaseolus vulgaris genes induced during the interaction with Rhizoctonia solani. Plant Cell Rep. 30, 1465–1473. doi: 10.1007/s00299-011-1055-5
Gutiérrez, S., McCormick, S. P., Cardoza, R. E., Kim, H.-S., Yugueros, L. L., Vaughan, M. M., et al. (2021). Distribution, function, and evolution of a gene essential for trichothecene toxin biosynthesis in Trichoderma. Front. Microbiol. 12. doi: 10.3389/fmicb.2021.791641
Gutiérrez, S., McCormick, S. P., Cardoza, R. E., Lindo, L., Alexander, N. J., Proctor, R. H. (2020). Trichoderma trichothecenes: beyond their toxic effect". In: New and Future Developments in Microbial Biotechnology and Bioengineering. Eds Gupta, V. K., Zeilinger, S., Singh, H. B., Druzhinina, I.. Chapter 12, pp 282–301. Elsevier, Amsterdam. doi: 10-1016/B978-0-12-819453-9-00013-1
Harris, L. J., Desjardins, A. E., Plattner, R. D., Nicholson, P. G., Butler, G., Young, J. C., et al. (1999). Possible role of trichothecene mycotoxins in virulence of Fusarium graminearum on maize. Plant Dis. 83, 954–960. doi: 10.1094/PDIS.1999.83.10.954
Hermosa, R., Cardoza, R. E., Rubio, M. B., Gutiérrez, S., Monte, E. (2014). “Secondary metabolism and antimicrobial metabolites of trichoderma,” in Biotechnology and biology of trichoderma. Eds. Gupta, V. K., Schmoll, M., Herrera-Estrella, A., Upadhyay, R. S., Druzhinina, I., Tuohy, M. G., Chapter 10, 125–137 Elsevier, Amsterdam.
Hoff, K. J., Stanke, M. (2013). WebAUGUSTUS – a web service for training AUGUSTUS and predicting genes in eukaryotes. Nucleic Acids Res. 41, W123.W128. doi: 10.1093/nar/gkt418
Izquierdo-Bueno, I., Moraga, J., Cardoza, R. E., Lindo, L., Hanson, J. R., Gutiérrez, S., et al. (2018). Relevance of the deletion of the Tatri4 gene in the secondary metabolome of Trichoderma arundinaceum. Org. Biomol. Chem. 16, 2955. doi: 10.1039/c8ob00338f
Jaklitsch, W. M. (2011). European Species of Hypocrea part II: species with hyaline ascospores. Fungal Diversity 48, 1–250. doi: 10.1007/s13225-011-0088-y
Jaklitsch, W. M., Voglmayr, H. (2015). Biodiversity of Trichoderma (Hypocreaceae) in southern Europe and macronesia. Stud. Mycol 80, 1–87. doi: 10.1016/j.simyco.2014.11.001
Kim, D., Paggi, J. M., Park, C., Bennett, C., Salzberg, S. L. (2019). Graph-based genome alignment and genotyping with HISAT2 and HISAT-genotype. Nat. Biotechnol. 37, 907–915. doi: 10.1038/s41587-019-0201-4
Kubicek, C. P., Steindorff, A. S., Chenthamara, K., Manganiello, G., Henrissat, B., Zhang, J., et al. (2019). Evolution and comparative genomics of the most common Trichoderma species. BMC Genom. 20, 485. doi: 10.1186/s12864-019-5680-7
Kumar, S., Shukla, V., Dubey, M. K., Upadhyay, R. S. (2021). Activation of defense response in common bean against stem rot disease triggered by Trichoderma erinaceum and Trichoderma viride. J. Bas Microbiol. 61, 910–922. doi: 10.1002/jobm.202000749
Lee, H. B., Kim, Y., Jin, H. Z., Lee, J. J., Kim, C.-J., Park, J. Y., et al. (2005). A new Hypocrea strain producing harzianum a cytotoxic to tumour cell lines. Lett. Appl. Microbiol. 40, 497–503. doi: 10.1111/j.1472-765X.2005.01719.x
Lehtonen, J. J., Somervuo, P., Valkonen, J. P. T. (2008). Infection with Rhizoctonia solani induces defense genes and systemic resistance in potato sprouts grown without light. Phytopathology 98, 1190–1198. doi: 10.1094/PHYTO-98-11-1190
Liao, J., Xu, Q., Xu, H., Huang, D. (2019). Natural farming improves soil quality and alters microbial diversity in a cabbage field in Japan. Sustain 11, 1–16. doi: 10.3390/su11113131
Lindo, L., Cardoza, R. E., Lorenzana, A., Casquero, P. A., Gutiérrez, S. (2020). Identification of plant genes putatively involved in the perception of fungal ergosterol-squalene. J. Integr. Plant Biol. 62 (7), 917–947. doi: 10.1111/jipb.12862
Lindo, L., McCormick, S. P., Cardoza, R. E., Brown, D. W., Kim, H.-S., Alexander, N. J., et al. (2018). Effect of deletion of a trichothecene toxin regulatory gene on the secondary metabolism transcriptome of the saprotrophic fungus Trichoderma arundinaceum. Fungal Genet. Biol. 119, 29–46. doi: 10.1016/j.fgb.2018.08.002
Lindo, L., McCormick, S. P., Cardoza, R. E., Kim, H.-S., Brown, D. W., Alexander, N. J., et al. (2019). Role of Trichoderma arundinaceum tri10 in regulation of terpene biosynthetic genes and in control of metabolic flux. Fungal Genet. Biol. 122, 31–46. doi: 10.1016/j.fgb.2018.11.001
Livak, K. J., Schmittgen, T. D. (2001). Analysis of relative gene expression data using real-time quantitative PCR and the 2-ΔΔCt method. Methods 25, 402–408. doi: 10.1006/meth.2001.1262
Lopes, F. A. C., Steindorff, A. S., Geraldine, A. M., Brandao, R. S., Monteiro, V. N., Júnior, M. L., et al. (2012). Biochemical and metabolic profiles of Trichoderma strains isolated from common bean crops in the Brazilian cerrado, and potential antagonism against Sclerotinia sclerotiorum. Fungal Biol. 116, 815–824. doi: 10.1016/j.funbio.2012.04.015
Mahé, F., Czech, L., Stamatakis, A., Quince, C., de Vargas, C., Dunthorn, M., et al. (2021). Swarm v3: Towards ter-scale amplicon clustering. Bioinformatics 38 (1), 267–269. doi: 10.1093/bioinformatics/btab493
Malmierca, M. G., Barua, J., McCormick, S. P., Izquierdo-Bueno, I., Cardoza, R. E., Alexander, N. J., et al. (2015). Novel aspinolide production by Trichoderma arundinaceum with a potential role in Botrytis cinerea antagonistic activity and plant defence priming. Environ. Microbiol. 17, 1103–1118. doi: 10.1111/1462-2920.12514
Malmierca, M. G., Cardoza, R. E., Alexander, N. J., McCormick, S. P., Collado, I. G., Hermosa, R., et al. (2013). Relevance of trichothecenes in fungal physiology: disruption of tri5 in Trichoderma arundinaceum. Fungal. Genet. Biol. 53, 22–23. doi: 10.1016/j.fgb.2013.02.001
Malmierca, M. G., Cardoza, R. E., Alexander, N. J., McCormick, S. P., Hermosa, R., Monte, E., et al. (2012). Involvement of Trichoderma trichothecenes in the biocontrol activity and induction of plant defense-related genes. Appl. Environ. Microbiol. 78, 4856–4868. doi: 10.1128/QEM.00385-12
Malmierca, M. G., Izquierdo-Bueno, I., McCormick, S. P., Cardoza, R. E., Alexander, N. J., Barua, J., et al. (2016). Trichothecenes and aspinolides produced by trichoderma arundinaceum regulate expression of Botrytis cinerea genes involved in virulence and growth. Environ. Microbiol. 18, 3991–4004. doi: 10.1111/1462-2920.13410
Martin, M. (2011). Cutadapt removes adapter sequences from high-throughput sequencing reads. EMBnet.journal 17 (1), 10–12. doi: 10.14806/ej.17.1.200
Mayo-Prieto, S., Campelo, M. P., Lorenzana, A., Rodríguez-González, A., Reinoso, B., Gutiérrez, S., et al. (2020a). Antifungal activity and bean growth promotion of Trichoderma strains isolated from seed vs soil. Eur. J. Plant Pathol. 158, 817–828. doi: 10.1007/s10658-020-02069-8
Mayo-Prieto, S., Cominelli, E., Sparvoli, F., González-López, O., Rodríguez-González, A., Gutiérrez, S., et al. (2016). Development of a qPCR strategy to select bean genes involved in plant defense response and regulated by the Trichoderma velutinum- Rhizoctonia solani interaction. Front. Plant Sci. 7. doi: 10.3389/fpls.2016.01109
Mayo-Prieto, S., Gutiérrez, S., Malmierca, M. G., Lorenzana, A., Campelo, M.--., Hermosa, R., et al. (2015). The influence of Rhizoctonia solani and Trichoderma spp. in growth of bean (Phaseolus vulgaris L.) and in the induction of plant defense-related genes. Front. Plant Sci. 6. doi: 10.3389/fpls.2015.00685
Mayo-Prieto, S., Rodríguez-González, A., Lorenzana, A., Gutiérrez, S., Casquero, P. A. (2020b). Influence of substrates in the development of bean and in pathogenicity of Rhizoctonia solani JG kühn. Agronomy 10 (5), 707. doi: 10.3390/agronomy10050707
McLaughlin, J. E., Bin-Umer, M. A., Tortora, A., Mendeze, N., McCormick, S., Tumer, N. E. (2009). A genome-wide screen in Saccharomyces cerevisiae reveals a critical role for the mitochondria in the toxicity of a trichothecene mycotoxin. Proc. Natl. Acad. Sci. U.S.A. 106, 21883–21888. doi: 10.1073/pnas.0909777106
Medema, M. H., Blin, K., Cimermancic, P., de Jager, V., Zakrewski, P., Fischbach, M. A., et al. (2011). antiSMASH: Rapid identification, annotation and analysis of secondary metabolite biosynthesis gene clusters. Nucleic Acids Res. 39, W339–W346. doi: 10.1093/nar/gkr466
Minh, B. Q., Hahn, M. W., Lanfer, R. (2020). New methods to calculate concordance factors for phylogenomic datasets. Mol. Biol. Evol. 37 (9), 2727–2733. doi: 10.1093/molbev/msaa106
Ministerio de Agricultura Pesca y Alimentación (2019). “Superficies y producciones de cultivos- leguminosas grano,” in Anuario de estadística- estadísticas agrarias y alimentación. Madrid, España. Available at: https://www.mapa.gob.es/es/estadistica/temas/publicaciones/anuario-de-estadistica/2019/default.aspx?parte=3&capitulo=07&grupo=2&seccion=1.
Nguyen, L.-T., Schmidt, H. A., von Haeseler, A., Minh, B. Q. (2015). IQ-TREE: A fast and effective stochastic algorithm for estimating maximum like- lihood phylogenies. Mol. Biol. Evol. 32, 268–274. doi: 10.1093/molbev/msu300
Nielsen, K. F., Gräfenhan, T., Zafari, D., Thrane, U. (2005). Trichothecene production by Trichoderma brevicompactum. J. Agric. Food. Chem. 53, 8190–8196. doi: 10.1021/jf051279b
Nilsson, R. H., Larsson, K.-H., Taylor, A. F. S., Bengtsson-Palme, J., Jeppesen, T. S., Schigel, D., et al. (2019). The UNITE database for molecular identification of fungi: handling dark taxa and parallel taxonomic classifications. Nucleic Acids Res. 47 (D1), D259–D264. doi: 10.1093/nar/gky1022
O´Donnell, K., McCormick, S. P., Busman, M., Proctor, R. H., Ward, T. J., Doehring, G., et al. (2018). Marasas et al. 1984 ''Toxigenic Fusarium species: identity and mycotoxicology''. Mycologia 110, 1059–1080. doi: 10.1080/00275514.2018.1519773
Okumwai, H., Yoshino, N., Suglura, Y., Sugamata, M., Hintikka, E.-L., Jarvis, B., et al. (1999). “Trichothecenes as potent inducers of apoptosis,” in Bioaerosols, fungi and mycotoxins: health effects, assessment, prevention, and control. Ed. Johanning, E. (Albany, N.Y: Boyd Printing Co., Inc.), 221–231.
Pereira, J. L., Queiroz, R. M. L., Charneau, S. O., Felix, C. R., Ricart, C. A. O., Lopes da Silva, F., et al. (2014). Analysis of Phaseolus vulgaris response to its association with Trichoderma harzianum (ALL-42) in the presence of absence of the phytopathogenic fungi Rhizoctonia solani and Fusarium solani. PloS One 9, e98234. doi: 10.1371/journal.pone.0098234
Pertea, M., Pertea, G. M., Antonescu, C. M., Chang, T. C., Mendell, J. T., Salzberg, S. L. (2015). StringTie enables improved reconstruction of a transcriptome from RNA-seq reads. Nat. Biotechnol. 33, 290–295. doi: 10.1038/nbt.3122
Proctor, R. H., McCormick, S. P., Gutiérrez, S. (2020). Genetic bases for variation in structure and biological activity of trichothecene toxins produced by diverse fungi. Appl. Microbiol. Biotechnol. 104, 5185–5199. doi: 10.1007/s00253-020-10612-0
Proctor, R. H., McCormick, S. P., Kim, H.-S., Cardoza, R. E., Stanley, A. M., Lindo, L., et al. (2018). Evolution of structural diversity of trichothecenes, a family of toxins produced by plant pathogenic and entomopathogenic fungi. PloS Pathog. 14 (4), e1006946. doi: 10.1371/journal.ppat.1006946
Restovich, S. B., Andriulo, A. E., Portela, S. I. (2012). Introduction of cover crops in a maize-soybean rotation of the humid pampas: Effect on nitrogen and water dynamics. Field Crops Res. 128, 62–70. doi: 10.1016/J
Robinson, M. D., McCarthy, D. J., Smyth, G. K. (2010). edgeR: a bioconductor package for differential expression analysis of digital gene expression data. Bioinformatics 26, 139–140. doi: 10.1093/bioinformatics/btp616
Rodríguez-González, A., Frontela, A., Da Silva, P. H., Gutiérrez, S., Casquero, P. A. (2017). Inhibitory activity of Beauveria bassiana and Trichoderma spp. on the insect pests Xylotrechus arvicola (Coleoptera: Cerambycidae) and Acanthoscelides obtectus (Coleoptera: Chrisomelidae: Bruchinae). Environ. Monit. Assess 189, 12. doi: 10.1007/s10661-016-5719-z
Ryu, S. M., Lee, H. M., Song, E. G., Seo, Y. H., Lee, J., Guo, Y., et al. (2017). Antiviral activities of trichothecenes isolated from Trichoderma albolutescens against pepper mottle virus. J. Agric. Food Chem. 65, 4273–4279. doi: 10.1021/acs
Sivasithamparam, K., Ghisalberti, E. L. (1998). “Secondary metabolism in Trichoderma and Gliocladium” in Trichoderma and gliocladium, vol. 1 . Eds. Harman, G. E., Kubicek, C. P. (London, UK: Taylor & Francis), 139–191.
Stanke, M., Keller, O., Gunduz, I., Hayes, A., Waack, S., Morgenstern, B. (2006). AUGUSTUS: ab initio prediction of alternative transcripts. Nucleic Acids Res. 34, W435–W439. doi: 10.1093/nar/gkl200
Straus, D. C. (2009). Mods, mycotoxins, and sick building syndrome. Toxicol. Ind. Health 25, 617–635. doi: 10.1177/0748233709348287
Sun, J., Pei, Y., Li, E., Li, W., Hyde, K. D., Yin, K. D., et al. (2016). A new species of Trichoderma hypoxylon harbours abundant secondary metabolites. Sci. Rep. 6, 37369. doi: 10.1038/srep37369
Tijerino, A., Cardoza, R. E., Moraga, J., Malmierca, M. G., Vicente, F., Aleu, J., et al. (2011). Overexpression of the trichodiene synthase gene tri5 increases trichodermin production and antimicrobial activity in Trichoderma brevicompactum. Fungal Genet. Biol. 48, 285–296. doi: 10.1016/j.fgb.2010.11.012
Vaidya, G., Lohman, D. J., Meier, R. (2011). SequenceMatrix: Concatenation software for the fast assembly of multi-gene datasets with character set and codon information. Cladistics 27, 171–180. doi: 10.1111/j.1096-0031.2010.00329.x
Valenciano, J. B., Casquero, P. A., Boto, J. A., Marcelo, V. (2006). Evaluation of the occurrence of root rots on bean plants (Phaseolus vulgaris) using different sowing methods and with different techniques of pesticide application. N.Z. J. Crop Horticul. Sci. 34, 291–298. doi: 10.1080/01140671.2006.9514419
Keywords: biological control, gene-clusters, metabolomics, plant-fungal interaction, secondary metabolites, sesquiterpenes, transcriptomics
Citation: Cardoza RE, Mayo-Prieto S, Martínez-Reyes N, McCormick SP, Carro-Huerga G, Campelo MP, Rodríguez-González Á, Lorenzana A, Proctor RH, Casquero PA and Gutiérrez S (2022) Effects of trichothecene production by Trichoderma arundinaceum isolates from bean-field soils on the defense response, growth and development of bean plants (Phaseolus vulgaris). Front. Plant Sci. 13:1005906. doi: 10.3389/fpls.2022.1005906
Received: 28 July 2022; Accepted: 18 October 2022;
Published: 14 November 2022.
Edited by:
Omer Frenkel, Agricultural Research Organization (ARO), IsraelReviewed by:
Manish Kumar Dubey, Galgotias University, IndiaAmit K. Jaiswal, Purdue University, United States
Copyright © 2022 Cardoza, Mayo-Prieto, Martínez-Reyes, McCormick, Carro-Huerga, Campelo, Rodríguez-González, Lorenzana, Proctor, Casquero and Gutiérrez. This is an open-access article distributed under the terms of the Creative Commons Attribution License (CC BY). The use, distribution or reproduction in other forums is permitted, provided the original author(s) and the copyright owner(s) are credited and that the original publication in this journal is cited, in accordance with accepted academic practice. No use, distribution or reproduction is permitted which does not comply with these terms.
*Correspondence: Santiago Gutiérrez, cy5ndXRpZXJyZXpAdW5pbGVvbi5lcw==; Pedro A. Casquero, cGFjYXNsQHVuaWxlb24uZXM=